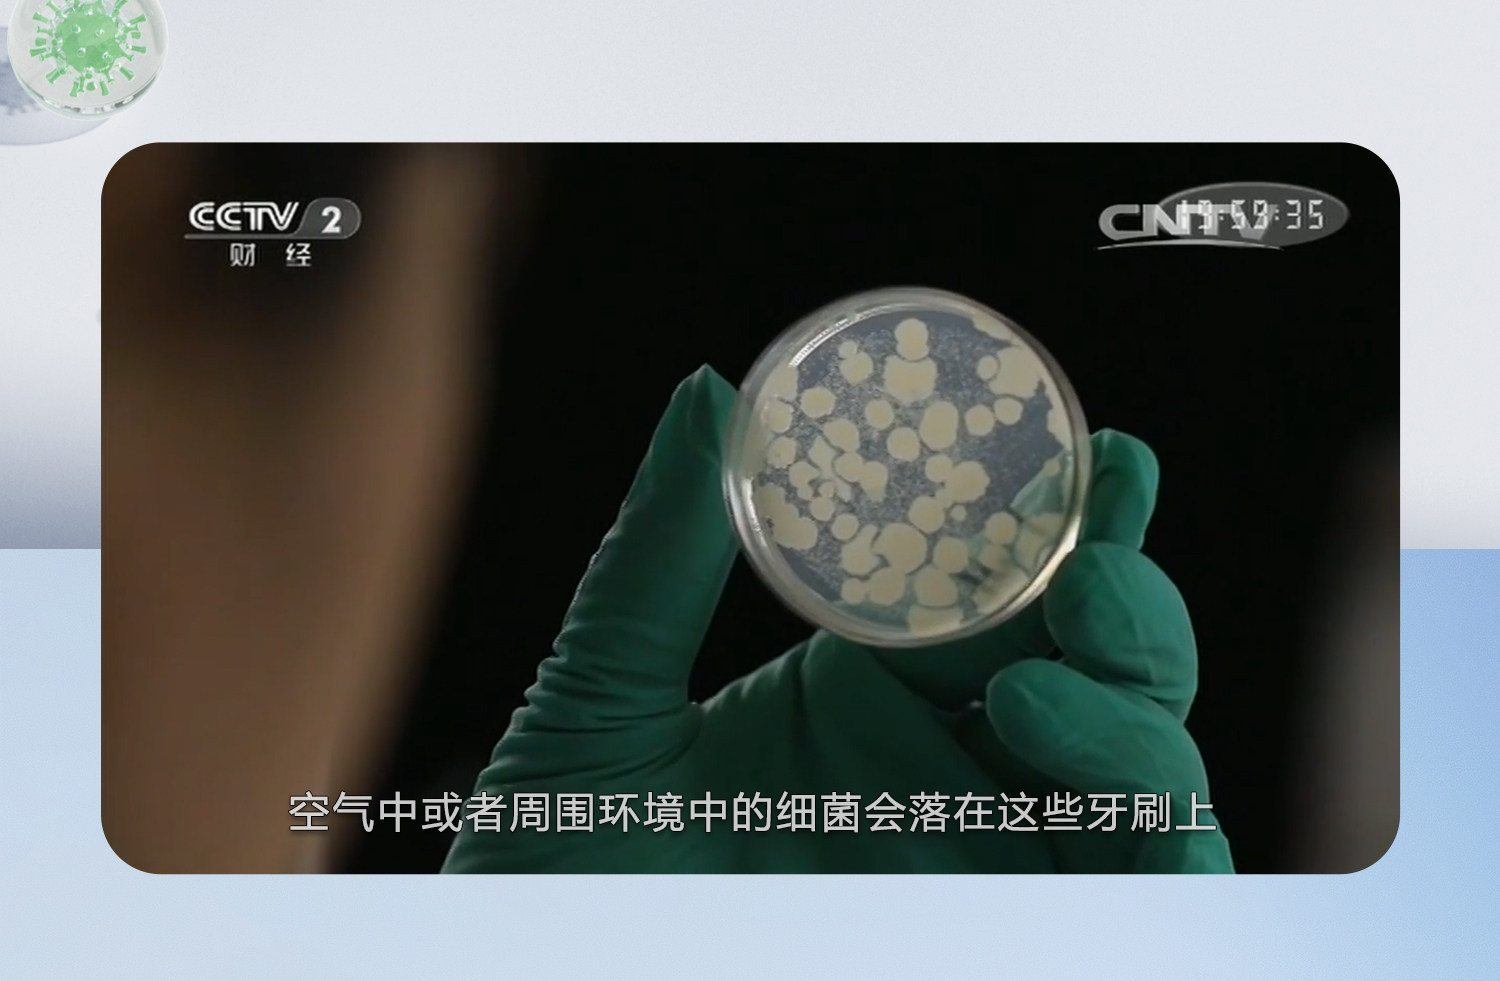

同诗 Зубная щетка, антибактериальный автоматический комплект для влюбленных, полностью автоматический, подарок на день рождения

Цена: 14 686руб. (¥699)
Артикул: 692479373640
Вес товара: ~0.7 кг. Указан усредненный вес, который может отличаться от фактического. Не включен в цену, оплачивается при получении.
Описание товараPHA+PGltZyBzcmM9Imh0dHBzOi8vaW1nLmFsaWNkbi5jb20vaW1nZXh0cmEvaTQvMjIxMTUxODQwMTIxNC9PMUNOMDFFckZZU0IxS3EzZHVOUFZZQV8hITIyMTE1MTg0MDEyMTQuanBnIiBhbGlnbj0iYWJzbWlkZGxlIj48aW1nIHNyYz0iaHR0cHM6Ly9pbWcuYWxpY2RuLmNvbS9pbWdleHRyYS9pMy8yMjExNTE4NDAxMjE0L08xQ04wMWZ6RUxqSTFLcTNnMWNiM0FXXyEhMjIxMTUxODQwMTIxNC5qcGciIGFsaWduPSJhYnNtaWRkbGUiPjxpbWcgc3JjPSJodHRwczovL2ltZy5hbGljZG4uY29tL2ltZ2V4dHJhL2kzLzIyMTE1MTg0MDEyMTQvTzFDTjAxRDBHM0I4MUtxM2lsbTI3OFBfISEyMjExNTE4NDAxMjE0LmpwZyIgYWxpZ249ImFic21pZGRsZSI+PGltZyBzcmM9Imh0dHBzOi8vaW1nLmFsaWNkbi5jb20vaW1nZXh0cmEvaTEvMjIxMTUxODQwMTIxNC9PMUNOMDFIOVpnb1YxS3EzaWZTVzY3Sl8hITIyMTE1MTg0MDEyMTQuanBnIiBhbGlnbj0iYWJzbWlkZGxlIj48aW1nIHNyYz0iaHR0cHM6Ly9pbWcuYWxpY2RuLmNvbS9pbWdleHRyYS9pNC8yMjExNTE4NDAxMjE0L08xQ04wMUFlTThRWDFLcTNpbk9jdUNLXyEhMjIxMTUxODQwMTIxNC5qcGciIGFsaWduPSJhYnNtaWRkbGUiPjxpbWcgc3JjPSJodHRwczovL2ltZy5hbGljZG4uY29tL2ltZ2V4dHJhL2kxLzIyMTE1MTg0MDEyMTQvTzFDTjAxWWlBTFhKMUtxM2lrUG1lQnhfISEyMjExNTE4NDAxMjE0LmpwZyIgYWxpZ249ImFic21pZGRsZSI+PGltZyBzcmM9Imh0dHBzOi8vaW1nLmFsaWNkbi5jb20vaW1nZXh0cmEvaTMvMjIxMTUxODQwMTIxNC9PMUNOMDE2N1FiWjQxS3EzaW1iS2JzYV8hITIyMTE1MTg0MDEyMTQuanBnIiBhbGlnbj0iYWJzbWlkZGxlIj48aW1nIHNyYz0iaHR0cHM6Ly9pbWcuYWxpY2RuLmNvbS9pbWdleHRyYS9pMi8yMjExNTE4NDAxMjE0L08xQ04wMWhGMkU0azFLcTNpa1BsaHptXyEhMjIxMTUxODQwMTIxNC5qcGciIGFsaWduPSJhYnNtaWRkbGUiPjxpbWcgc3JjPSJodHRwczovL2ltZy5hbGljZG4uY29tL2ltZ2V4dHJhL2kxLzIyMTE1MTg0MDEyMTQvTzFDTjAxOTRhY0tsMUtxM2loUFFLa0dfISEyMjExNTE4NDAxMjE0LmdpZiIgYWxpZ249ImFic21pZGRsZSI+PGltZyBzcmM9Imh0dHBzOi8vaW1nLmFsaWNkbi5jb20vaW1nZXh0cmEvaTMvMjIxMTUxODQwMTIxNC9PMUNOMDF4U0sxekcxS3EzaWxtM3paTV8hITIyMTE1MTg0MDEyMTQuZ2lmIiBhbGlnbj0iYWJzbWlkZGxlIj48aW1nIHNyYz0iaHR0cHM6Ly9pbWcuYWxpY2RuLmNvbS9pbWdleHRyYS9pMy8yMjExNTE4NDAxMjE0L08xQ04wMXk1SGV6UjFLcTNpaVBTT2tJXyEhMjIxMTUxODQwMTIxNC5qcGciIGFsaWduPSJhYnNtaWRkbGUiPjxpbWcgc3JjPSJodHRwczovL2ltZy5hbGljZG4uY29tL2ltZ2V4dHJhL2kyLzIyMTE1MTg0MDEyMTQvTzFDTjAxY3lzNlJWMUtxM2luT2NJcExfISEyMjExNTE4NDAxMjE0LmpwZyIgYWxpZ249ImFic21pZGRsZSI+PGltZyBzcmM9Imh0dHBzOi8vaW1nLmFsaWNkbi5jb20vaW1nZXh0cmEvaTMvMjIxMTUxODQwMTIxNC9PMUNOMDE4SWdIUHoxS3EzaWxtM3ZQbV8hITIyMTE1MTg0MDEyMTQuanBnIiBhbGlnbj0iYWJzbWlkZGxlIj48aW1nIHNyYz0iaHR0cHM6Ly9pbWcuYWxpY2RuLmNvbS9pbWdleHRyYS9pMi8yMjExNTE4NDAxMjE0L08xQ04wMUlrQTRjdTFLcTNpbG0zU0pkXyEhMjIxMTUxODQwMTIxNC5qcGciIGFsaWduPSJhYnNtaWRkbGUiPjxpbWcgc3JjPSJodHRwczovL2ltZy5hbGljZG4uY29tL2ltZ2V4dHJhL2kzLzIyMTE1MTg0MDEyMTQvTzFDTjAxVG9vMWx0MUtxM2loUU5mbmZfISEyMjExNTE4NDAxMjE0LmpwZyIgYWxpZ249ImFic21pZGRsZSI+PGltZyBzcmM9Imh0dHBzOi8vaW1nLmFsaWNkbi5jb20vaW1nZXh0cmEvaTEvMjIxMTUxODQwMTIxNC9PMUNOMDFETWVWbmUxS3EzaWV0cDZqc18hITIyMTE1MTg0MDEyMTQuanBnIiBhbGlnbj0iYWJzbWlkZGxlIj48aW1nIHNyYz0iaHR0cHM6Ly9pbWcuYWxpY2RuLmNvbS9pbWdleHRyYS9pMS8yMjExNTE4NDAxMjE0L08xQ04wMWlmUjJ5azFLcTNpbFJ1TGhGXyEhMjIxMTUxODQwMTIxNC5qcGciIGFsaWduPSJhYnNtaWRkbGUiPjxpbWcgc3JjPSJodHRwczovL2ltZy5hbGljZG4uY29tL2ltZ2V4dHJhL2kzLzIyMTE1MTg0MDEyMTQvTzFDTjAxa0gwdWNCMUtxM2lldGRFNXRfISEyMjExNTE4NDAxMjE0LmpwZyIgYWxpZ249ImFic21pZGRsZSI+PGltZyBzcmM9Imh0dHBzOi8vaW1nLmFsaWNkbi5jb20vaW1nZXh0cmEvaTEvMjIxMTUxODQwMTIxNC9PMUNOMDFBdGVmeEExS3EzaW1iTFkzWV8hITIyMTE1MTg0MDEyMTQuanBnIiBhbGlnbj0iYWJzbWlkZGxlIj48aW1nIHNyYz0iaHR0cHM6Ly9pbWcuYWxpY2RuLmNvbS9pbWdleHRyYS9pNC8yMjExNTE4NDAxMjE0L08xQ04wMTE3ckJGUTFLcTNpbk9kcU5FXyEhMjIxMTUxODQwMTIxNC5qcGciIGFsaWduPSJhYnNtaWRkbGUiPjxpbWcgc3JjPSJodHRwczovL2ltZy5hbGljZG4uY29tL2ltZ2V4dHJhL2kyLzIyMTE1MTg0MDEyMTQvTzFDTjAxdHZJVGJRMUtxM2laOTVrUW1fISEyMjExNTE4NDAxMjE0LmpwZyIgYWxpZ249ImFic21pZGRsZSI+PGltZyBzcmM9Imh0dHBzOi8vaW1nLmFsaWNkbi5jb20vaW1nZXh0cmEvaTMvMjIxMTUxODQwMTIxNC9PMUNOMDFlSkZoRDIxS3EzaWV0ZGQzN18hITIyMTE1MTg0MDEyMTQuanBnIiBhbGlnbj0iYWJzbWlkZGxlIj48aW1nIHNyYz0iaHR0cHM6Ly9pbWcuYWxpY2RuLmNvbS9pbWdleHRyYS9pNC8yMjExNTE4NDAxMjE0L08xQ04wMW1UUExCNDFLcTNpaVBRek9iXyEhMjIxMTUxODQwMTIxNC5qcGciIGFsaWduPSJhYnNtaWRkbGUiPjxpbWcgc3JjPSJodHRwczovL2ltZy5hbGljZG4uY29tL2ltZ2V4dHJhL2kzLzIyMTE1MTg0MDEyMTQvTzFDTjAxWE9wQ1FzMUtxM2laOTZZTHZfISEyMjExNTE4NDAxMjE0LmpwZyIgYWxpZ249ImFic21pZGRsZSI+PGltZyBzcmM9Imh0dHBzOi8vaW1nLmFsaWNkbi5jb20vaW1nZXh0cmEvaTEvMjIxMTUxODQwMTIxNC9PMUNOMDFISU1TTWwxS3EzaWtQbUI0ZV8hITIyMTE1MTg0MDEyMTQuanBnIiBhbGlnbj0iYWJzbWlkZGxlIj48aW1nIHNyYz0iaHR0cHM6Ly9pbWcuYWxpY2RuLmNvbS9pbWdleHRyYS9pMS8yMjExNTE4NDAxMjE0L08xQ04wMVNidlZsUTFLcTNpbG0yMnhxXyEhMjIxMTUxODQwMTIxNC5qcGciIGFsaWduPSJhYnNtaWRkbGUiPjxpbWcgc3JjPSJodHRwczovL2ltZy5hbGljZG4uY29tL2ltZ2V4dHJhL2k0LzIyMTE1MTg0MDEyMTQvTzFDTjAxZVh5NGVpMUtxM2lpUUhNRjNfISEyMjExNTE4NDAxMjE0LmpwZyIgYWxpZ249ImFic21pZGRsZSI+PGltZyBzcmM9Imh0dHBzOi8vaW1nLmFsaWNkbi5jb20vaW1nZXh0cmEvaTMvMjIxMTUxODQwMTIxNC9PMUNOMDFNQVpSajkxS3EzaVo5NHdaSl8hITIyMTE1MTg0MDEyMTQuanBnIiBhbGlnbj0iYWJzbWlkZGxlIj48L3A+PGltZyBzcmM9Imh0dHBzOi8vd3d3Lm8wYi5jbi9pLnBocD90LnBuZyZyaWQ9Z3ctNC42NWRiNzJhMmJlNGQwJnA9MzU4NTU1MzM2OSZrPWUuY29tJnQ9MTcwODg4MDU0OSIgc3R5bGU9ImRpc3BsYXk6bm9uZSI+
Продавец:同诗旗舰店
Рейтинг:

Всего отзывов:0
Положительных:0
Добавить в корзину
- Информация о товаре
- Фотографии